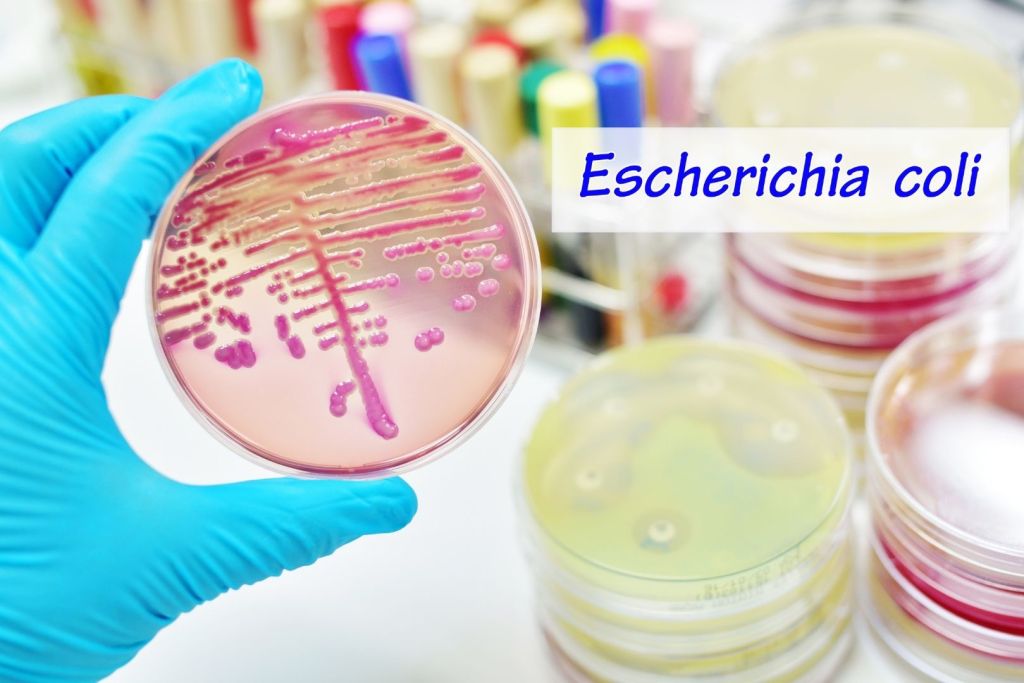
La E. coli puede provocar enfermedades graves, pero también es una herramienta habitual en la investigación y el desarrollo de nuevos fármacos

En los laboratorios de Cambridge, un equipo de biólogos sintéticos ha logrado algo que, hasta hace pocos años, sonaba más a ciencia ficción que a biología experimental: reconstruir el genoma de Escherichia coli para reducir su código genético de 64 a solo 57 codones. El trabajo, publicado en la revista Science, no solo abre una puerta a organismos con funciones imposibles en la naturaleza, sino que desafía una de las ideas más antiguas y universales de la biología: que el código genético, tal y como lo conocemos, es intocable.
La E. coli es mucho más que una bacteria de manual de microbiología. Está en el intestino de millones de personas y animales, es una herramienta fundamental en biotecnología y una de las especies más estudiadas del planeta. Su genoma, de unos cuatro millones de bases, sigue la misma lógica que el de casi todos los seres vivos: un lenguaje basado en 64 combinaciones posibles de tres letras —los famosos codones— que sirven para construir proteínas. De esos 64, 61 codifican aminoácidos y 3 son señales de parada. Y aquí está el punto clave: para fabricar las 20 piezas básicas que componen cualquier proteína, no hacen falta tantos codones. El sistema está lleno de redundancias.
Durante décadas, la ciencia se preguntó si esa redundancia tenía un propósito oculto o si era, como sugirió Francis Crick en los años 60, un “accidente congelado” de la evolución: algo que surgió por azar y quedó fijado porque cambiarlo implicaba riesgos catastróficos. Hoy, con Syn57 —el nombre de la nueva cepa—, tenemos una pista poderosa para resolver esa duda.
Más de 100.000 cambios y cuatro años de ingeniería
La magnitud del proyecto es difícil de exagerar. No hablamos de editar genes aquí y allá, sino de rediseñar por completo el genoma. Los investigadores dividieron el ADN en decenas de fragmentos, sustituyendo cada codón redundante por otro que cumpliera la misma función, y ensamblaron todo de nuevo. El resultado: más de 101.000 cambios y una versión de E. coli que funciona con siete codones menos que la original.
El trabajo exigió un proceso de prueba y error casi artesanal. En cada etapa, pequeños fragmentos del nuevo genoma se introducían en bacterias vivas para comprobar que seguían creciendo. Si no lo hacían, tocaba revisar la secuencia, detectar dónde se había roto alguna función esencial y reparar el fallo. Hubo que rediseñar genes que se solapaban, ajustar instrucciones de lectura y aprender, en tiempo real, cómo evitar daños colaterales en este rompecabezas molecular.
El precedente existía. En 2019, el mismo laboratorio presentó Syn61, una E. coli con tres codones menos que la versión natural, que se convirtió en un hito importante porque demostró la viabilidad de un código genético reducido. Aquella hazaña requirió 18.000 cambios; Syn57 multiplica por seis ese número. El salto no es solo técnico: es conceptual.
Una bacteria lenta… pero llena de posibilidades
Por ahora, Syn57 no es un prodigio de velocidad. Mientras la E. coli normal duplica su población en una hora, la versión de 57 codones tarda unas cuatro. Ese lastre podría resolverse con ajustes posteriores, pero incluso así, la nueva cepa es una plataforma con potencial enorme.
Uno de los objetivos más tentadores es la resistencia total a virus. Muchos bacteriófagos —virus que infectan bacterias— dependen de que su huésped lea correctamente sus genes. Si el código de lectura cambia, el virus “traduce” sus instrucciones de forma errónea y la infección fracasa. Para la industria biotecnológica, esto significaría producir proteínas, fármacos o enzimas sin riesgo de que un virus arruine el cultivo.
El otro gran frente está en la química de la vida. Con codones “liberados” de su función original, los científicos podrían reasignarlos para que codifiquen aminoácidos que no existen en la naturaleza. Esto abriría la puerta a proteínas con propiedades inéditas, capaces de catalizar reacciones químicas imposibles para la biología natural o de formar materiales con funciones avanzadas.
Una pista para un viejo misterio evolutivo
Más allá de sus posibles aplicaciones, Syn57 es un experimento que responde —parcialmente— a una pregunta de fondo: ¿por qué la vida necesita 64 codones si le bastarían poco más de veinte?
El hecho de que una bacteria viva con 57 codones demuestra que esa redundancia no es estrictamente necesaria. Esto inclina la balanza hacia la hipótesis de Crick: la universalidad del código genético podría ser una simple herencia histórica, no una obra maestra optimizada por la selección natural.
Esto no significa que eliminar codones sea trivial. Cada cambio exige vigilar un ecosistema genético donde pequeñas modificaciones pueden desencadenar problemas en cadena. El proceso de reducción está lejos de ser automático, y no está claro si es posible seguir acortando el código sin que la vida colapse.

Por otro lado, Syn57 también aporta una herramienta para la seguridad biológica. En un escenario hipotético donde bacterias modificadas se liberen accidentalmente al medio, su código genético alterado impediría que genes artificiales se transfirieran a especies naturales. El “idioma” sería incomprensible para ellas.
Esto no elimina todos los riesgos, pero añade una barrera significativa en un mundo donde la ingeniería genética es cada vez más accesible y potente.
Más allá de E. coli
Aunque el trabajo se haya centrado en una especie modelo, la lógica detrás de Syn57 podría aplicarse a otros microorganismos e incluso, en teoría, a células más complejas. La capacidad de reescribir el lenguaje básico de la biología es una frontera tecnológica con implicaciones enormes: desde medicamentos más seguros hasta organismos capaces de degradar contaminantes persistentes o producir bioplásticos más eficientes.
El desafío, como siempre, será equilibrar la innovación con la precaución. La historia de la biotecnología está llena de ejemplos de avances que, sin la regulación y el debate adecuados, pueden generar problemas imprevistos. En ese sentido, Syn57 es tanto una proeza técnica como una invitación a repensar qué significa “vida” cuando podemos reconstruirla pieza a pieza.